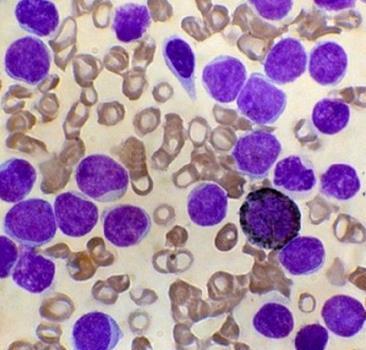

人成巨核细胞白血病细胞
|
|
|
- CAS号:
- 英文名:
- MEG-01
- 英文别名:
- MEG-01;MEG-01 Cells Line
- 中文名:
- 人成巨核细胞白血病细胞
- 中文别名:
- MEG01人白血病细胞;人慢性粒细胞性白血病细胞;人巨核细胞白血病细胞MEG01;MEG-01人成巨核白血病细胞细胞;MEG-01 人成巨核细胞白血病细胞系;MEG-01人成巨核细胞白血病传代细胞系;MEG-01细胞:人成巨核细胞白血病细胞系;MEG-01人成巨核细胞白血病细胞传代性好|带STR图谱;MEG-01人成巨核细胞白血病复苏细胞(附STR鉴定报告);MEG-01(人成巨核细胞白血病细胞)YB-71498HC
- CBNumber:
- CB82925705
- 分子式:
- 分子量:
- 0
- MOL File:
- Mol file
|
|
|
人成巨核细胞白血病细胞性质、用途与生产工艺
人成巨核细胞白血病细胞源自一位CML患者成巨核细胞转换期的骨髓细胞。细胞质因子VIII和表面球蛋白IIb/IIIa,高碘酸-Schiff(PAS)反应,α醋酸萘酯酶和酸性磷酸酶阳性。髓过氧化物酶,α丁酸萘酯酶,氯化醋酸AS-D萘苯酚酯酶和碱性磷酸酶阴性。用单克隆抗体BA-1(抗B细胞,粒性白细胞),HPL-3(抗球蛋白IIb/IIIa)和20.3(抗单核细胞,血小板)染色成阳性。其他淋巴和骨髓类抗体成阴性。
人成巨核细胞白血病细胞
人成巨核细胞白血病细胞培养基及培养冻存条件准备:
1)准备RPMI-1640培养基(RPMI-1640:GIBCO,货号31800022,添加NaHCO3 1.5g/L,D-葡萄糖2.5g/L,丙酮酸钠0.11g/L),90%;优质胎牛血清,10%。
2)培养条件:气相:空气,95%;二氧化碳,5%。温度:37摄氏度,培养箱湿度为70%-80%。
3)冻存液:90%完全培养基,10%DMSO,现用现配。液氮储存。
人源(Homo sapiens)
骨髓(Bone marrow)
悬浮生长(Suspension)
55岁(55 years)
巨核细胞(Megakaryoblast)
慢性粒细胞性白血病 (chronic myelogenous leukemia)
人成巨核细胞白血病细胞
上下游产品信息
上游原料
下游产品
人成巨核细胞白血病细胞 相关搜索:
- 细胞系
- 细胞系-人细胞系
- ATCC细胞-ATCC细胞系
- 细胞-原代细胞
- 细胞生物学-细胞系
- 细胞-细胞系
- 细胞系-human细胞系
- 生物试剂
- 有机化学品
- MEG01人白血病细胞
- MEG-01(人成巨核细胞白血病细胞)YB-71498HC
- 人慢性粒细胞性白血病细胞
- MEG-01细胞 (人成巨核细胞白血病细胞)(STR鉴定正确)CL-0498
- MEG-01细胞 (人成巨核细胞白血病细胞)(STR鉴定正确)
- MEG-01人成巨核细胞白血病细胞传代性好|带STR图谱
- MEG-01人成巨核细胞白血病细胞复苏中心|完全培养基|鉴定图谱
- MEG01人成巨核细胞白血病细胞系保种库(附带STR基因图谱)
- 人巨核细胞白血病细胞MEG01
- MEG-01人成巨核白血病细胞细胞
- MEG-01|人成巨核细胞白血病血清培养细胞(免费送STR)
- MEG-01:人成巨核细胞白血病复苏细胞(提供STR鉴定图谱)
- MEG-01人成巨核细胞白血病复苏细胞(附STR鉴定报告)
- MEG-01人成巨核细胞白血病传代细胞系
- MEG-01细胞:人成巨核细胞白血病细胞系
- MEG-01 人成巨核细胞白血病细胞系
- MEG-01 Cells Line
- MEG-01